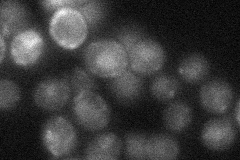
YLR102C
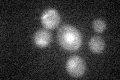
YLR102C

View description
Subunit of the Anaphase-Promoting Complex/Cyclosome (APC/C), which is a ubiquitin-protein ligase required for degradation of anaphase inhibitors, including mitotic cyclins, during the metaphase/anaphase transition
Localization:
Intensity:
Fold change:
Significance:
-
C’ GFP library in SD

below threshold17.11 -
N' NOP1pr-GFP in SD

cytosol,nucleus46.498 -
N' TEF2pr-mCherry in SD

punctate,nucleus18.2841 -
N' NATIVEpr-GFP in SD
punctate,nucleus24.8804 -
N' TEF2pr-VC and Cyto-VN in SD

#N/A0 -
C’ GFP library in SD+DTT

cytosol181.05No -
C’ GFP library in SD+H2O2
cytosol17.241No -
C’ GFP library in Starvation Media

cytosol18.81.09No -
C’ GFP library on the background of Pup2-DaMP

below threshold -
C’ GFP library on the background of CCT mutant

below threshold17.33551.01303No
